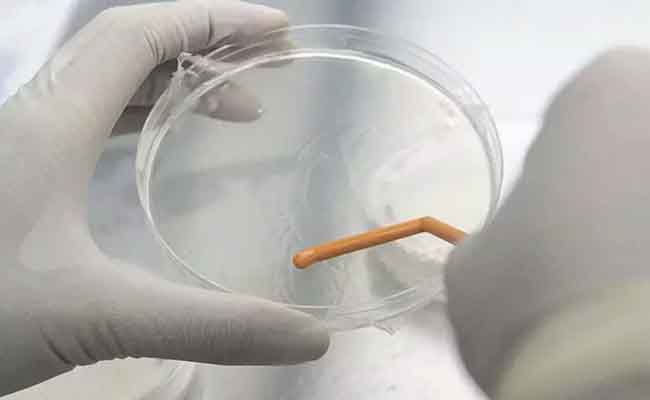

ചൈനയിൽ വ്യാപകമായി പടരുന്ന ഹ്യൂമൻ മെറ്റന്യൂമോവൈറസ് (എച്ച്.എം.പി.വി) കേസ് ഇന്ത്യയില് രണ്ടു പേര്ക്ക് സ്ഥിരീകരിച്ചു. ബംഗ്ലൂരില് എട്ട് മാസം പ്രായമുള്ള ആണ്കുഞ്ഞിന്ആയിരുന്നു ആദ്യം രോഗം സ്ഥിരീകരിച്ചത്. പിന്നാലെ മൂന്ന് മാസം പ്രായമായ പെണ് കുഞ്ഞിന് രണ്ടാമതായി രോഗം സ്ഥിരീകരിച്ചു.
ശ്വാസതടസ്സത്തെ തുടര്ന്നാണ് കുഞ്ഞിനെ ആശുപത്രിയില് പ്രവേശിച്ചത്.
ഇരുവരും ഒരേ ആശുപത്രിയിലാണ് ചികിത്സയില് കഴിയുന്നത്. രണ്ട് കുട്ടികള്ക്കും വിദേശയാത്രാ പശ്ചാത്തലമില്ല. കുട്ടികളെയും രക്ഷിതാക്കളെയും ഐസോലേഷനില് പ്രവേശിപ്പിച്ചു. ഉറവിടം കണ്ടെത്താന് കഴിയാത്തത് ആശങ്കയുണ്ടാക്കുന്നുണ്ട്.
ചൈനീസ് വേരിയന്റ് ആണോ കുട്ടികള്ക്ക് സ്ഥിരീകരിച്ചത് എന്നത് വ്യക്തമല്ല. പരിശോധന തുടരുമെന്ന് കര്ണ്ണാടക ആരോഗ്യവകുപ്പ് അറിയിച്ചു. എട്ടുമാസം പ്രായമുള്ള കുഞ്ഞിനെ ശക്തമായ പനിയെ തുടര്ന്നാണ് ആശുപത്രിയില് പ്രവേശിപ്പിച്ചത്. തുടര്ന്ന് നടത്തിയ പരിശോധനയിലാണ് രോഗം സ്ഥിരീകരിച്ചത്. രോഗലക്ഷണങ്ങള് പ്രകടിപ്പിക്കുന്ന കുട്ടികളില് എച്ച്എംപിവി സ്കീനിംഗ് നടത്തണമെന്ന് കര്ണാടക ആരോഗ്യമന്ത്രാലയം അറിയിച്ചിരുന്നു.
Rose Malayalam Updates
അയർലണ്ട് വാർത്തകൾ ഉടൻ ലഭിക്കുവാൻ ഞങ്ങളുടെ വാട്സാപ്പ് ഗ്രൂപ്പിൽ അംഗമാകൂ.
JOIN GROUP NOW
Comments